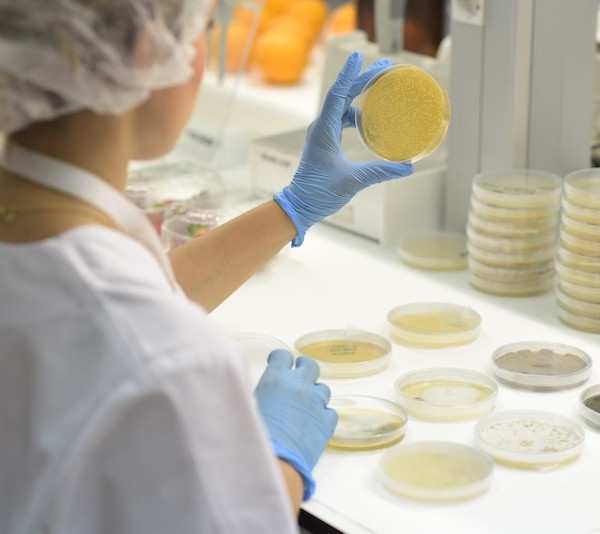
Bioestimulantes de Trichodex y su efecto sobre la sequía.

Valencia acogerá el próximo jueves 26 de febrero, la Asamblea de FEPEX en la que se abordarán cinco claves trascendentales para el futuro del sector de frutas y hortalizas y de flores y plantas: las relaciones con la distribución europea, puesto que Europa supone más del 96% de la exportación española; la competencia de países terceros que irrumpen en el mercado comunitario generando desventajas competitivas respecto a los productores europeos, la necesidad de fitosanitarios y de mano de obra y la futura PAC.
En la reunión participarán responsables de las asociaciones ubicadas en las principales zonas de producción del país: Comunidad Valenciana, Andalucía, Murcia, Cataluña, Extremadura, Castilla y León, Castilla-La Mancha, Aragón, La Rioja y Navarra.
En la parte pública de la Asamblea de FEPEX, que será la número 67, se analizará “La nueva PAC, los aspectos económicos” a cargo del director del Servicio de Estudios de la Fundación Grupo Cajamar, Ignacio Atance. Atance explicará el giro radical que supondrá la futura PAC, en la que los planes estratégicos serán sustituidos por los “Planes País”, abordando también los cambios que tendrán lugar en el ámbito hortofrutícola y en concreto en la regulación y financiación de las organizaciones de productores.
Disponibilidad de fitosanitarios
Intervendrá también el director general de AEPLA, Carlos Palomar, quien analizará la disponibilidad de fitosanitarios bajo la nueva normativa comunitaria, poniendo el foco en el paquete Omnibus Food&Feed.
La directora de Empleo, Diversidad y Protección Social de CEOE, Rosa Santos, expondrá los principales cambios previstos en política laboral durante este año 2026, como la nueva subida del SMI aprobada, ayer, en el Consejo de ministros y su repercusión en los costes de la actividad productiva.
El director de FEPEX, Ignacio Antequera, abordara las dinámicas en las relaciones con la distribución europea, teniendo en cuenta que Europa es el primer destino de la exportación española de frutas y hortalizas, representando el 96% de lo exportado por España y también es el primer destino de la exportación de flores y plantas.
Y el director técnico de la Federación, Luis Martín expondrá el reto que supone la competencia de países terceros y cómo esta competencia está transformando el mercado comunitario.
La Asamblea Comenzará con la bienvenida del presidente de FEPEX, Cecilio Peregrín y el director comercial de Cajamar, Francisco Martinez Ibañez. Y será clausurada por el Consejero de Agricultura, Agua, Ganadería y Pesca de la Generalitat Valenciana, Miguel Barrachina. Intervendrá también la directora de FRUIT ATTRACTION, María José Sánchez.
La Asamblea se celebrará en Valencia, en el Edificio Cajamar, situado en el Paseo de la Alameda 34, y la parte publica se desarrollará desde las 12 a las 14,15 horas,.
Cuenta con el patrocinio del Grupo Cooperativo Cajamar y Fruit Attraction y con la colaboración de las asociaciones integradas en FEPEX y con sede en la Comunidad Valenciana: la Asociación Española del Kaki; la Federación Provincial de Empresarios de frutos y Productos Hortícolas de Alicante, Fexphal; la Asociación de Cosecheros Exportadores de España, ACEC; la Asociación Profesional de Flores, Plantas y Tecnología Hortícola de la Comunidad Valenciana, Asfplant y la Asociación Valenciana de Empresarios Viveristas de Vid, AVEV.